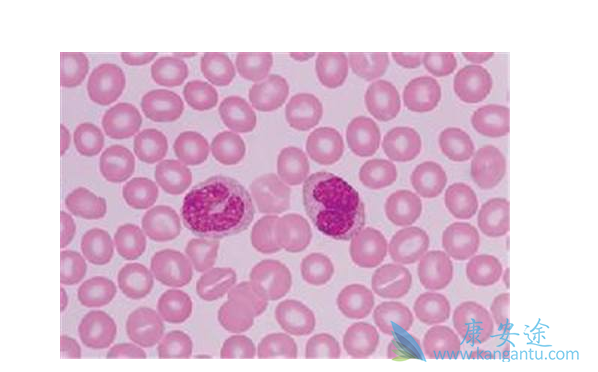
������ϸ���԰�Ѫ��

其实粒细胞就是一种由细胞中包含颗粒体产生的白细胞,如果是在正常的转态下它会由补体调节蛋白调控,并由骨髓中的造血干细胞分化而成。但是,某些体内的费城染色体(Ph)会发现染色体易位现象:也就是九号染色体中长链的ABL基因,会与二十二号染色体上长链的BCR基因发生并列性易位,而产生一种新的融合基因。
发生费城染色体易位之后,就会导致人体骨髓中的主要粒细胞从此不受控制地增长,并在血液中不断地积累,无限增生。这种粒细胞恶性增殖的疾病,也就是慢性粒细胞性白血病。慢粒白血病的发病演变分为慢性期,加速期与急变期。在慢性期阶段中,患者通常没有什么明显的病症,或是仅有一些乏力、左侧疼痛、关节疼痛或者腹胀的不适感。只有在验血时,才会发现白细胞总量有偶然性的增多。慢性期的长度一般各有不同,取决于疾病何时被诊断以及治疗的介入时间。如果没有进行治疗的话,疾病就会进入加速期。
慢粒白血病在加速期阶段,患者的症状与表现与急性骨髓性白血病患者很相似。而且加速期非常重要,因为此时已经暗示疾病在持续恶化,并将向急变期转化。在加速期阶段中,药物治疗通常已经效果甚微了。从慢性期到加速期,一般患者可以渡过3到5年,如果药物控制效果好,病人也可以维持慢性期数年,甚至十数年。
详情请到 医疗 https://www.kangantu.com/news/
















请简单描述您的疾病情况,我们会有专业的医学博士免费为您解答问题(24小时内进行电话回访)